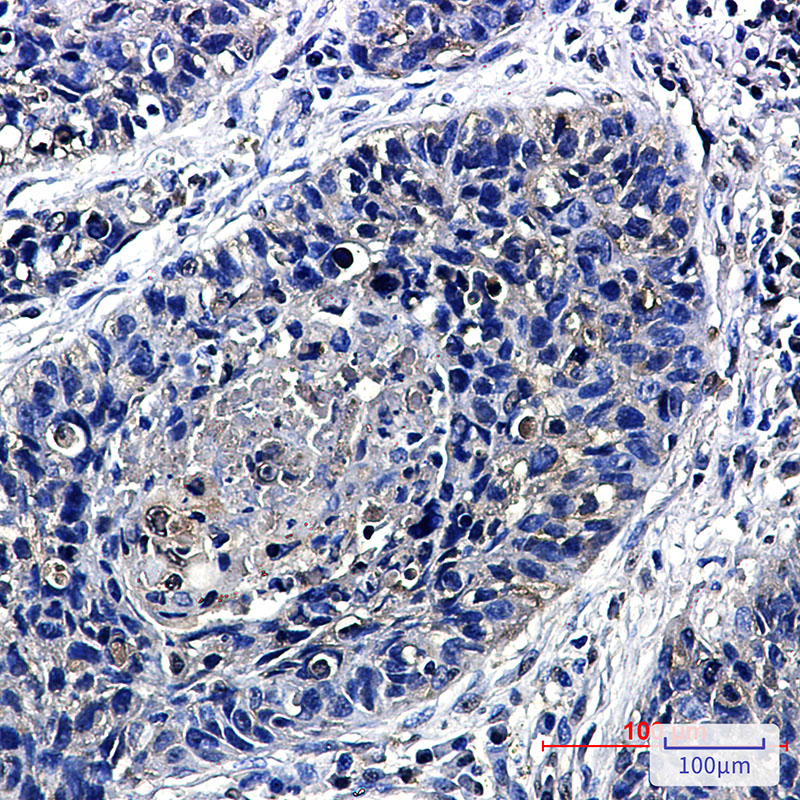

-
分类: 科研抗体货号: P22127别名: CAT2; ECAC1; OTRPC3应用: WB,IP反应种属: Human,Mouse,Rat
-
分类: 科研抗体货号: P22109别名: TOP1; DNA topoisomerase 1; DNA topoisomerase I应用: WB,IHC,IF反应种属: Human,Mouse,Rat
-
分类: 科研抗体货号: P22119别名: C20orf97; NIPK; SINK; SKIP3; TRB3; Trib3; Tribbles homolog 3; Tribbles pseudokinase 3; Tribbles3应用: WB,IP反应种属: Human
-
分类: 科研抗体货号: P22126别名: TF6; HMSNP; SPG57; TRKT3应用: WB,IP,IHC反应种属: Human,Mouse,Rat
-
分类: 科研抗体货号: P22136别名: APACD; PHLP3应用: WB,IHC反应种属: Human
-
分类: 科研抗体货号: P22118别名: LOQS; Prbp; tarbp2; TRBP; TRBP1; TRBP2应用: WB,IP,IHC,IF反应种属: Human,Mouse,Rat
-
分类: 科研抗体货号: P22125别名: TF6; HMSNP; SPG57; TRKT3应用: WB,IHC,IF反应种属: Human,Mouse,Rat
-
分类: 科研抗体货号: P22134别名: HuF2; ZGRF6应用: WB,IHC,IF反应种属: Human,Rat
-
分类: 科研抗体货号: P22117别名: TRAX应用: WB反应种属: Human,Mouse,Rat
-
分类: 科研抗体货号: P22124别名: TRIM25; EFP; RNF147; ZNF147; E3 ubiquitin/ISG15 ligase TRIM25; Estrogen-responsive finger protein; RING finger protein 147; Tripartite motif-containing protein 25; Ubiquitin/ISG15-conjugating enzyme TRIM25; Zinc finger protein 147应用: WB,IP,IF反应种属: Human,Rat

鄂公网安备42018502007531号
鄂公网安备42018502007531号

